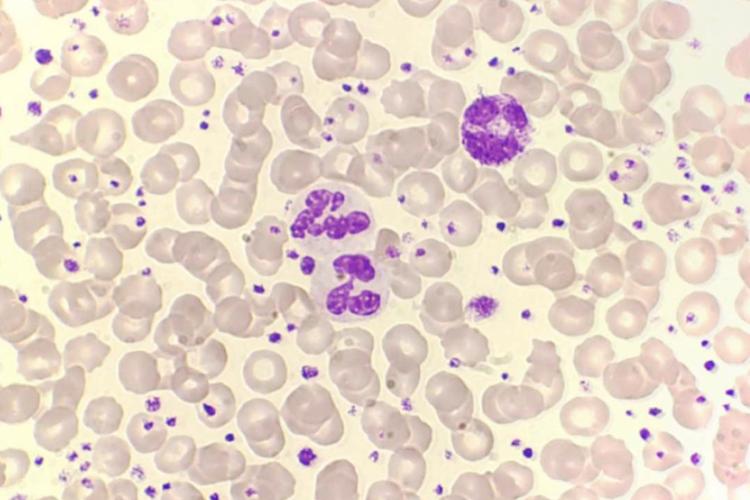

血小板有核嗎深入解析:揭開血小板無核之謎與其關鍵生理功能
Table of Contents
揭開血小板的神秘面紗:它們真的沒有細胞核嗎?
在我們人體複雜的循環系統中,血液扮演著運輸氧氣、營養物質並清除廢物的重要角色。而血液中的三大主要細胞成分——紅血球、白血球和血小板——各自肩負著獨特的生理功能。其中,血小板(Platelets),又稱為凝血細胞,以其在止血過程中的關鍵作用而聞名。然而,當我們談論到細胞結構時,一個常見的問題便是:
「血小板有核嗎?」
答案是明確的:正常成熟的血小板是沒有細胞核的。這個特性不僅是其形態上的重要標誌,更是理解其獨特功能與生理壽命的關鍵。本文將深入探討血小板為何沒有細胞核、這種結構上的「缺失」如何影響其功能,以及它在我們身體止血機制中的核心作用。
血小板的基本結構:為何它沒有細胞核?
要理解血小板為何缺乏細胞核,我們必須追溯其起源。血小板並非完整的細胞,而是由骨髓中一種巨大的多核細胞——巨核細胞(Megakaryocyte)——的細胞質碎片斷裂而成。
- 起源於巨核細胞: 巨核細胞是骨髓中體積最大的細胞,它在發育過程中會經歷核內複製,形成多倍體核,但細胞本身並不分裂。隨後,巨核細胞的細胞質會向骨髓血竇內延伸,形成偽足(pseudopods),這些偽足再經由一系列複雜的斷裂和剪切,釋放出數以千計的微小碎片,這些碎片就是我們所熟知的血小板。
- 碎片的本質: 正因為血小板是細胞質的「碎片」,而非完整細胞分裂的產物,它們在形成時就沒有繼承細胞核。它們攜帶的是巨核細胞細胞質中的各種細胞器和分子。
因此,血小板被歸類為「血細胞樣結構」或「無核細胞片段」。
血小板的內部組成:沒有細胞核,它們還有什麼?
儘管缺乏細胞核,血小板卻絕非空無一物。為了執行其複雜的止血功能,它們內部擁有一系列精密的結構和分子:
- 粒線體(Mitochondria): 這些是細胞的「能量工廠」,負責生成ATP,為血小板的活化、形狀改變和分泌活動提供能量。
- 儲存顆粒(Storage Granules): 這是血小板功能的核心所在,主要分為兩種:
- α-顆粒(Alpha-granules): 體積較大,內含多種與凝血、血管生成、細胞黏附和傷口癒合相關的蛋白質,如血小板第四因子(PF4)、血小板衍生生長因子(PDGF)、纖維蛋白原(Fibrinogen)、馮威爾白蘭德因子(vWF)等。
- 緻密顆粒(Dense granules / Delta granules): 體積較小,內含非蛋白類物質,如ADP(腺苷二磷酸)、ATP(腺苷三磷酸)、血清素(Serotonin)和鈣離子(Calcium ions),這些物質在血小板活化和聚集過程中扮演關鍵的訊息傳遞者。
- 細胞骨架(Cytoskeleton): 由微絲(Actin filaments)和微管(Microtubules)組成,賦予血小板形狀並使其能夠迅速改變形態,例如在活化後從圓盤狀變為星狀,並延伸偽足。
- 開放性小管系統(Open Canalicular System, OCS): 這是細胞膜內陷形成的一系列相互連接的管道,增加了血小板的表面積,並作為活化後釋放顆粒內容物的通道。
- 緻密管系統(Dense Tubular System, DTS): 這是平滑內質網的殘留,負責儲存鈣離子,並在血小板活化時釋放,是信號傳導的重要環節。
所有這些內部組件都嵌合在一個由細胞膜(Cell Membrane)包裹的結構中,細胞膜上還鑲嵌著多種受體,用於識別損傷信號和與其他細胞或分子結合。
細胞核的缺乏如何影響血小板的功能與壽命?
血小板沒有細胞核,這看似是一個結構上的「缺陷」,實則賦予了它們高度特化的功能並影響其生命週期:
- 無法進行蛋白質合成與自我修復: 細胞核是細胞的「控制中心」,負責儲存遺傳物質DNA,並指揮細胞合成新的蛋白質。由於血小板沒有細胞核,它們無法從頭合成新的蛋白質來修復損傷或補充耗盡的分子。這意味著血小板的功能在很大程度上取決於其形成時從巨核細胞繼承而來的蛋白質和酶。
- 壽命短暫: 正因為無法自我修復和更新其組成成分,血小板的壽命非常短暫,通常在血液中循環約7到10天後就會被脾臟或其他網狀內皮系統清除。這與紅血球(約120天)或某些白血球(數小時到數年不等)的壽命形成鮮明對比。
- 高度特化的功能: 細胞核的缺失使血小板能夠將其所有「資源」和內部空間都投入到執行其核心功能——止血上。它們是高度專業化的「急救隊員」,其形態和內容物都為迅速響應血管損傷而優化。它們不需要像其他細胞一樣執行複雜的代謝和生長功能。
這種「用完即丟」的策略,確保了止血系統的效率和響應速度。
血小板的核心功能:止血的關鍵角色
儘管無核,血小板卻是人體止血(Hemostasis)過程中不可或缺的參與者。它們主要負責初級止血(Primary Hemostasis),即在血管受損時迅速形成血小板栓(Platelet Plug)來堵塞出血點。
這個過程通常分為幾個階段:
- 黏附(Adhesion): 當血管內皮受損暴露出血管下層的膠原蛋白時,血小板會透過其表面的特定受體(如糖蛋白Ib/IX/V,結合vWF;以及糖蛋白Ia/IIa,結合膠原蛋白)迅速黏附到損傷部位。
- 活化(Activation): 一旦黏附,血小板會被活化。活化的血小板會改變形狀(從圓盤狀變為不規則狀並伸出偽足),並從其內部顆粒中釋放多種化學物質(如ADP、血清素、血栓素A2等)。這些物質不僅進一步招募和活化更多的血小板,還會啟動凝血級聯反應。
- 聚集(Aggregation): 活化的血小板會透過其表面新暴露的糖蛋白IIb/IIIa受體,與纖維蛋白原(Fibrinogen)結合,從而相互連接並形成一個鬆散的血小板栓。這個栓子隨後會被凝血級聯反應生成的纖維蛋白網加固,形成穩固的血凝塊。
血小板在這些環節中協同作用,共同保障了血管受損後能夠迅速有效地止血,避免過度失血。
臨床上的意義:血小板計數的重要性
由於血小板在止血中的關鍵作用,其數量和功能狀態是評估個體凝血能力的重要指標。透過全血細胞計數(Complete Blood Count, CBC),可以檢測血小板計數。
- 正常血小板計數: 一般成人約為150,000至450,000個/微升(µL)。
- 血小板低下症(Thrombocytopenia): 當血小板計數低於正常範圍時,可能導致凝血功能障礙,增加出血風險,如瘀斑、紫癜、牙齦出血、鼻出血,嚴重時甚至內臟出血。原因多樣,包括骨髓生成不足、血小板破壞過度或脾臟功能亢進等。
- 血小板增多症(Thrombocytosis): 當血小板計數高於正常範圍時,可能增加血栓形成的風險,導致心臟病發作、中風或其他血管阻塞性疾病。原因可能為原發性(骨髓增生性疾病)或繼發性(如感染、炎症、手術後、缺鐵性貧血等)。
因此,理解血小板的結構、功能與其無核的特性,對於臨床診斷和治療相關疾病具有重要意義。
總結
「血小板有核嗎?」這個看似簡單的問題,引導我們深入探討了血小板這一獨特血細胞片段的生物學奧秘。其無細胞核的特性,是其作為巨核細胞碎片的本質,也是其高度特化為止血工具的關鍵。雖然沒有細胞核,血小板卻滿載著執行其任務所需的一切「工具」——粒線體、多種顆粒、細胞骨架和精密的膜系統。這種結構上的「簡化」,使其能夠在血管損傷時迅速活化、聚集,高效地完成止血的使命。
了解血小板的這些特性,不僅有助於我們更好地理解人體複雜的生理機制,也為臨床上診斷和治療出血或血栓性疾病提供了重要的基礎。
常見問題 (FAQ)
Q1:為何血小板沒有細胞核?
A1: 血小板並非完整的細胞,而是由骨髓中的巨核細胞(Megakaryocyte)的細胞質斷裂形成的碎片。由於它們是「碎片」,所以在形成過程中沒有繼承細胞核,這使它們能夠更專注於止血功能。
Q2:沒有細胞核的血小板,內部還有什麼重要的成分?
A2: 儘管無核,血小板內部仍富含執行功能的關鍵成分,包括提供能量的粒線體、含有凝血因子和生長因子的α-顆粒、含有ADP和血清素的緻密顆粒,以及維持形狀和支持變形的細胞骨架等,這些都對止血至關重要。
Q3:血小板的壽命大約是多久?為什麼?
A3: 血小板的壽命相對短暫,通常在血液中循環約7到10天。這是因為它們沒有細胞核,無法合成新的蛋白質來修復自身或更新耗損的組件,因此功能會逐漸衰退並被清除。
Q4:血小板數量異常會導致什麼問題?
A4: 血小板數量過低(血小板低下症)會增加出血的風險,例如容易瘀青或流鼻血;而數量過高(血小板增多症)則可能增加血栓形成的風險,導致心臟病或中風等問題。
Q5:如何檢測我的血小板數量是否正常?
A5: 您的血小板數量可以透過進行「全血細胞計數」(Complete Blood Count, CBC)來檢測。這是一種常見的血液檢查,可以提供包括血小板在內的多種血細胞資訊,幫助醫生評估您的凝血功能。